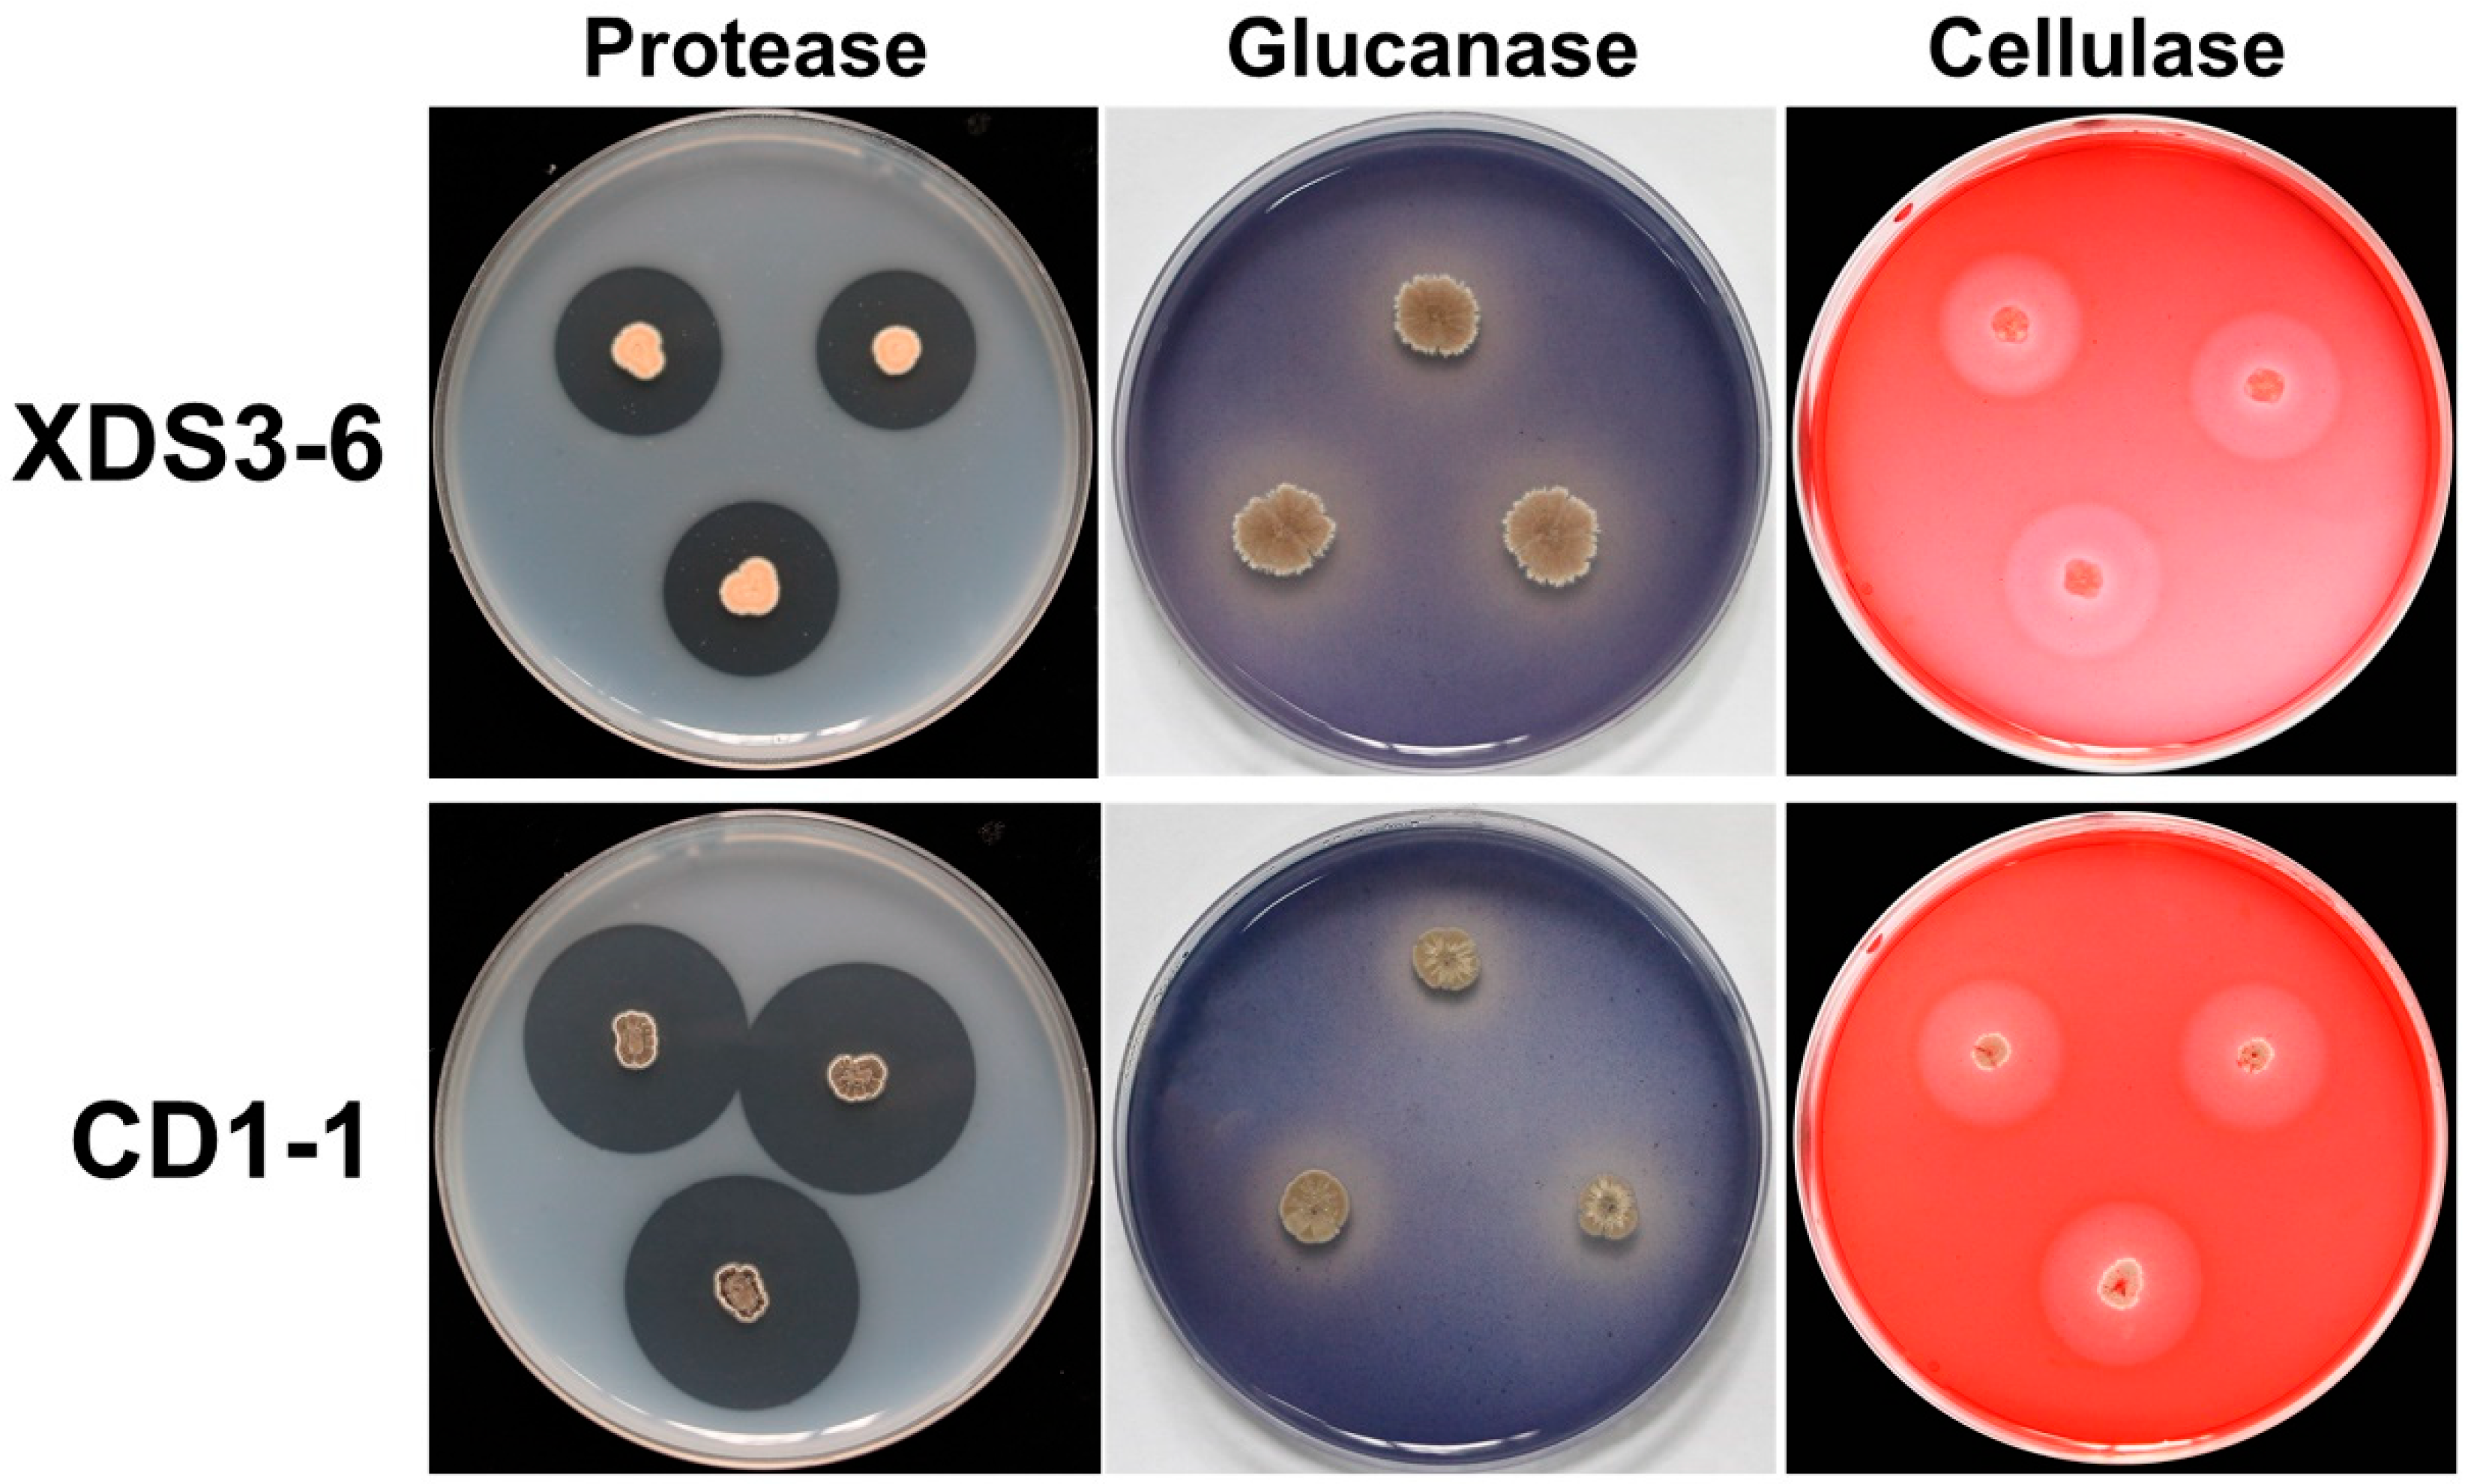
Plants 14 02195 g003

1. Introduction
Clubroot, a globally significant soil-borne disease, presents considerable economic impacts, primarily resulting from the infection of
Plasmodiophora brassicae. This pathogen predominantly infects economically valuable crops within the
Brassicaceae, including rapeseed, radish, mustard, and cabbage [
1]. The pathogenic process involves spore reproduction, primarily through cortex infection, and can also involve asexual short-cycle processes [
2]. Moreover, during the root hair infection stage, some secondary zoospores can stay in the soil, where they await the opportunity for subsequent root hair infection [
3]. Therefore, clubroot is particularly difficult to be controlled.
Currently, the primary measures for controlling clubroot involve the application of chemical agents. However, excessive use of chemical pesticides can lead to severe environmental pollution and potential risks to human health [
4]. Hence, the development of safe, effective, and environmentally friendly biocontrol agents holds significant importance for clubroot prevention and management [
5]. Biocontrol bacteria exert their antibacterial effects through mechanisms such as parasitism, antibiosis, competition, and growth promotion. They also have the capacity to modulate plant physiological processes, promoting host plant growth and development [
6]. Additionally, these bacteria can induce host resistance, bolstering the plant’s defense mechanisms against pathogens. For instance, Hu et al. demonstrated the effective biological control of Chinese cabbage clubroot by
Streptomyces alfalfae, which also influenced the diversity of bacterial and fungal communities in Chinese cabbage rhizosphere while enhancing plant growth in greenhouse conditions [
7]. Samiah et al. isolated and screened eight bacterial strains from cabbage rhizosphere soil, showing their ability to inhibit the germination of dormant
P. brassicae spores [
8].
Biocontrol bacteria also produce secondary metabolites, including alkaloids, antibiotics, siderophores, and hydrolytic enzymes, to hinder the growth of pathogenic bacteria [
9]. These metabolites can disrupt the integrity of cell membrane structures by inhibiting protein and nucleic acid synthesis and related enzyme activities, altering the permeability of the cell membranes of pathogenic bacteria and thereby impeding their growth. Arie et al. reported the effective control of clubroot using
Phoma glomerata JCM 9972, with its secondary metabolite aciloxetin demonstrating potent cabbage clubroot control. In addition, 250 μg/mL Epoxydon was found to completely inhibit the germination of dormant
P. brassicae spores [
10]. Li et al. showed that secondary metabolites produced by
Bacillus subtilis XF-1, including funzimycin-like cyclic peptides, promoted the lysis of dormant spores [
11]. Malik et al. isolated 37 chitin-decomposing bacteria, with strains TD9, TD11, TD15, and TD24 exhibiting strong antagonistic effects against
Rhizoctonia,
Fusarium, and
Anthracnose in plate experiments [
12]. Zhang et al. identified that lipopeptide compounds produced by
Bacillus velezensis Jt84 disrupted the mycelium morphology of
Magnaporthe oryzae, with iturin playing a pivotal role, significantly reducing rice blast incidence during the rice seedling stage [
13]. In summary, biocontrol bacteria offer a promising and environmentally friendly approach for clubroot management, as they employ various mechanisms and secondary metabolites to combat pathogenic bacteria and enhance plant resistance. These findings underscore the potential of biocontrol agents in mitigating clubroot-related challenges.
Numerous studies have demonstrated that biocontrol bacteria and their fermentation broths can elicit alterations in plant defense enzymes, resistance-associated substances, and plant hormones, including phenylalanine ammonia-lyase (PAL), peroxidase (POD), polyphenol oxidase (PPO), salicylic acid (SA), jasmonic acid (JA), and ethylene (ET), among others, thus enhancing plant resistance mechanisms. Following pathogen infection, resistant plant varieties typically maintain elevated enzyme activities of PPO, POD, and PAL [
14]. For instance,
Bacillus siamensis LZ88 can induce POD and PPO to enhance tobacco resistance against brown spot disease of tobacco caused by
Alternaria alternata [
14]. Furthermore, biocontrol bacteria have been shown in numerous recent studies to boost POD, PPO, and PAL activities, as well as augment SA and JA content in plants, thereby fortifying plant disease resistance [
15]. Biocontrol bacteria induce host resistance by promoting the expression of enzymatic activities (e.g., POD and PPO) in the host, thereby illuminating the pathway of their action mechanism.
In this research, we conducted antagonistic assessments involving 13 strains of actinomycetes, and we successfully identified two biocontrol bacterial strains that effectively inhibited P. brassicae infection in cabbage. The comprehensive analysis of their biocontrol efficacy, functional attributes, underlying mechanisms, and colonization within cabbage roots will establish a robust foundation for the study of biological management of cabbage clubroot.
3. Discussion
Clubroot, a disease characterized by its extensive distribution and rapid dissemination, poses a significant threat to Brassicaceae crops, leading to adverse effects on their growth, vitality, and economic value. However, the causative agent of clubroot obligately parasitizes the roots of living plants and cannot be cultured in vitro, making its prevention and treatment a formidable challenge [
21]. Current strategies primarily involve breeding resistant plant varieties and resorting to chemical control methods [
22]. However, these approaches often fall short in adapting to the evolving diversity of pathogen strains, raising concerns about safety, environmental pollution, and the emergence of fungicide-resistant strains associated with chemical control [
23]. Embracing eco-friendly and sustainable biological control strategies can address these limitations, although their effectiveness typically lags behind chemical interventions, and stability can vary [
24]. Moreover, the practical use of biological source pesticides in agriculture remains limited, so it is crucial to search for and develop biocontrol agents for the management of clubroot. For instance,
Phoma glomerata JCM 9972, with its secondary metabolite aciloxetin, and
Bacillus subtilis XF-1, including funzimycin-like cyclic peptides, can effectively promote the lysis of dormant spores of
P. brassicae to reduce clubroot [
10,
11]. Thus, biocontrol offers a promising and environmentally friendly approach for clubroot management, as it employs various mechanisms and secondary metabolites to limit the growth and spread of pathogens and enhance plant resistance.
In our study, we identified two
Streptomyces strains, XDS3-6 and CD1-1, that effectively suppressed root hair infections caused by
P. brassicae, resulting in a remarkable 64% inhibition of cabbage clubroot development. To optimize our experiment, we introduced cabbage root exudates into the culture medium, adjusted pH levels to a weakly acidic range, and maintained a dark environment at 16 °C to enhance the germination rate of dormant spores. Within the hydroponic system, we standardized the dormant spore concentration at 10
7 CFU/mL. Given that dark and weakly acidic conditions promote
P. brassicae infection, our experimental design thoughtfully selected optimal culture conditions for infection assessment, which was performed on the 9th day [
25]. Furthermore, we considered that excessively concentrated actinomycetes fermentation filtrate might harm hydroponic seedlings, while overly diluted concentrations might not affect the root hair infection process. These meticulous arrangements significantly enhanced the inhibitory effects of XDS3-6 and CD1-1 on clubroot development.
Notably, XDS3-6 and CD1-1 are classified as
Streptomyces species, specifically identified as
S. virginiae and
S. cinnamonensis, respectively. Previous research has revealed the remarkable capabilities of
S. virginiae, including its proficiency in transforming and degrading sterol compounds. Additionally, this strain produces Virginiamycin M (VM), a polyketide–peptide antibiotic hybrid, with the peptide antibiotic Virginiamycin S (VS) as its synergistic counterpart. VM and VS belong to the streptogramin family and exhibit potent synergistic antibacterial activity. Moreover, their secondary metabolism leads to the production of diverse novel sterol compounds, which exhibit inhibitory properties against a range of eukaryotic microorganisms [
26,
27,
28]. In contrast,
S. cinnamonensis can produce avidin-like biotin-binding proteins (streptavidins C1 and C2) that inhibit the mycelial growth of
Fusarium oxysporum [
29]. It is also capable of producing Monensin (a polyether ionophore antibiotic), which demonstrates remarkable anticoccidial and antitumor properties [
30]. In sterile culture solutions,
Streptomyces xanthophaeus strain T3-5 notably exhibits a substantial anti-rot effect on harvested strawberries, resulting in decreased titratable acidity and vitamin C content, as well as a delay in fruit firmness [
31]. Our study extends the scope of biocontrol applications for these two
Streptomyces species and elucidates their efficacy in inhibiting
P. brassicae.
Given the structural similarities between the dormant sporangia wall of
P. brassicae and fungal cell walls, our experiment focused primarily on selecting fungal pathogens for assessing the antifungal spectrum [
32]. Thus, we chose the major components of fungal cell walls—namely proteins, glucans, cellulose, and chitin—as indicators to evaluate the ability of actinomycete strains CD1-1 and XDS3-6 to secrete hydrolases capable of degrading these four components. The results demonstrated that strain XDS3-6 produced glucanase, protease, and cellulase, while strain CD1-1 produced protease and glucanase. Furthermore, this study revealed that strain CD1-1 displayed significantly higher protease production compared to strain XDS3-6—the transparent zone diameter generated by CD1-1 was 16.8 mm larger than that produced by XDS3-6. Moreover, during the broad-spectrum screening of antifungal activity against pathogenic fungi, strain CD1-1 demonstrated more potent antifungal effects than strain XDS3-6 against
P. nicotiae,
P. vexans,
S. sclerotiorum,
T. cucumeris, and
P. capsici. These results suggest that the inhibitory rates of strains XDS3-6 and CD1-1 on pathogenic fungal growth could be associated with protease activity. These findings suggest that the inhibitory rates of strain XDS3-6 and strain CD1-1 on pathogenic fungi growth may be correlated with protease activity.
The ability of biocontrol strains to colonize plant roots plays a critical role in their capacity to exert stable effects and resist external environmental influences [
33]. The use of antibiotic markers has gained significant research attention in this context [
34,
35]. For instance, rifampicin was employed as a marker to label the highly effective biocontrol strain
Zhihengliuella aestuarii B18, which demonstrates inhibitory effects against
P. brassicae. This marked strain could colonize the rhizosphere soil for a minimum of 45 days, with the highest bacterial colonization observed on the 10th day, and continued presence within plant roots on the 24th day [
36]. These findings underscore the importance of colonization by biocontrol strains in managing
P. brassicae infection in Chinese cabbage. The clubroot pathogen,
P. brassicae initiates its infection process by first aggregating and adhering to cabbage roots before proceeding to invade through root hairs, resulting in swelling and differentiation into gall-like structures. This process adversely affects water and nutrient absorption by the roots [
37]. When biocontrol actinomycetes (
Pseudomonas fluorescens PCL1751) preemptively occupy plant root niches, they engage in competitive interactions with
Agrobacterium tumefaciens for space and nutrients [
35]. Consequently, this occupation significantly disrupts the invasion process and impact of
P. brassicae, effectively preventing the infection of cabbage by
P. brassicae. However, it should be noted that in this experiment, antibiotics were used to label strains CD1-1 and XDS3-6, and the two labeled strains that had colonized Chinese cabbage were recovered [
35]. Consequently, we were unable to directly observe the specific localization of biocontrol strain colonization on the roots, nor could we directly observe changes in
P. brassicae colonization following the application of actinomycetes [
38]. Further experiments are warranted to substantiate the content of anti-
P. brassicae strains that compete with
P. brassicae for space and nutrients within plant roots.
In summary, our investigation identified 2 Streptomyces strains, XDS3-6 and CD1-1, from a pool of 13 tested strains, which exhibit remarkable efficacy in inhibiting Chinese cabbage clubroot disease. These strains possess a unique ability to colonize Chinese cabbage root systems, leading to potent inhibitory effects. These have several inhibitory mechanisms, including proteases that facilitate the degradation of P. brassicae cell walls, and they activate the host plant’s resistance defense mechanisms. This dual mechanism approach not only prevents clubroot disease but also enhances overall disease resistance in Chinese cabbage. These findings significantly contribute to the theoretical foundation for implementing biological control strategies to manage clubroot diseases in Chinese cabbage.
4. Materials and Methods
4.1. Materials and Growth Conditions
P. brassicae was collected from the swollen roots of cabbage in the Xiannv Mountain area of Chongqing and stored in a −20 °C freezer [
39].
P. nicotiae,
P. vexans,
B. cinerea,
C. nicotianae,
S. sclerotiorum,
T. cucumeris,
P. capsici,
P. delicense, and
R. stolonifer (provided by the Southwest University) were maintained by our laboratory and used for evaluating the broad-spectrum resistance of XDS3-6 and CD1-1.
Disinfected Chinese cabbage (B. rapa subsp. Pekinensis, ‘Degao 536’, a variety widely cultivated in Chongqing, purchased from an agricultural materials business department in Beibei District, Chongqing) seeds were sown on sterile wet filter paper and germinated at 25 °C in an incubator (Shanghai Yiheng Instruments Co., Ltd., Shanghai, China), for 3 days, then the seedlings were transferred to individual centrifuge tubes containing 2 mL of Hoagland nutrient solution (Shanghai Yuanye Biotechnology Co., Ltd., Shanghai, China). Subsequently, the seedings were incubated in a controlled environment with a temperature of 16 °C, a relative humidity of 70%, and a light cycle of 16 hours of illumination followed by 8 hours of darkness and optimal humidity for a duration of 7 days. After this incubation period, were gathered the root exudates from the seedlings and sterilized them using a bacterial filter.
4.2. Fermentation Filtrate
Initially, actinomycetes were introduced into Gauserime synthetic agar medium. Following a 5-day incubation period, two 8 mm actinomycetes cakes were generated and subsequently inoculated into 20 mL of Gauserime synthetic liquid medium. This liquid medium was cultured at 28 °C with agitation at 180 rpm for 7 days. Subsequently, the fermentation filtrate from the 13 strains was adjusted to a concentration of 1 × 10
7 CFU/mL for use in the subsequent experiments [
16].
4.3. Determination of Antifungal Activity
Initially, the broad-spectrum antifungal activity against nine pathogenic fungi, namely
P. nicotiae,
P. vexans,
B. cinerea,
C. micotianae,
S. sclerotiorum,
T. cucumeris,
P. capsici,
P. delicense, and
R. stolonifer, was determined using the plate confrontation assay. To conduct this assay, four distinct actinomycetes strains were inoculated at four equidistant points positioned 25 mm away from the center of the Petri dish. Antagonistic actinomycetes were similarly inoculated on both sides, 25 mm from the central point, and two 30 mm straight lines were drawn to create a cross-shaped pattern. These cultures were then incubated for three days, with an 8 mm agar plug placed at the central point. For the control group, pathogenic fungi were inoculated at the center of the Petri dish without the addition of actinomycetes. Each experimental setup was replicated three times. The inhibition rate (%) was calculated using the following formula:
This formula was used to determine the percentage of inhibition based on the difference in colony diameters between the control and treatment groups.
4.4. The Germination of Dormant Spores and Infection of Root Hair of P. brassicae
We prepared dormant spore suspensions of
P. brassicae using a standardized method [
39], adjusting the final suspension to a spore concentration of 1 × 10
7 CFU/mL using a hemocytometer. Chinese cabbage root exudates served as the culture medium. In sterilized Erlenmeyer flasks, 5 mL of root exudates, 0.5 mL of dormant spore suspension, and 0.5 mL of strain fermentation filtrate were combined. These flasks were then cultured under dark conditions at 24 °C. A Gauserime synthetic liquid medium was used as a control, and each treatment was replicated three times. On the 5th day, dormant spore germination was observed under a microscope. The methodology for evaluating the germination of
P. brassicae resting spores was optimized based on Wu’s protocol [
40]. Spores were stained with 1% orcein (dissolved in 45% acetic acid) for 10–15 s. Non-germinated spores appeared colored under the microscope, while uncolored spores were considered to have germinated. The spore germination rate and germination inhibition rate were calculated.
The cabbage seeds were sown on sterile wet filter paper and germinated in an incubator at 25 °C for 3 days. The seedlings were then transplanted into 10 mL light-proof centrifuge tubes filled with Hoagland nutrient solution for hydroponic culture. After five days, dormant P. brassicae spores and fermentation filtrate were inoculated into the centrifuge tubes. The final concentration of dormant spores was 107 CFU/mL. In the treatment group, the fermentation filtrate was added at a 1:30 (v/v) ratio to the Hoagland solution, while the control group received Hoagland nutrient solution only. After nine days of hydroponic cultivation, the seedling roots were washed with water, dyed with a fluorescent pink dyeing solution (Beijing Solarbio Science & Technology Co., Ltd., Bejing, China) for 30 min, excess dyeing solution was rinsed, and root hair infection was observed under a microscope.
4.5. In Vivo Anti-Clubroot Test
We prepared fermentation filtrates of strains CD1-1 and XDS3-6 at a concentration of 10
7 CFU/mL, as well as a suspension of
P. brassicae resting spores at 2.5 × 10
8 spores/mL. We irrigated the roots of Chinese cabbage plants at the four true-leaf stage (10–25 days) with the fermentation filtrates of the strain XDS3-6 and
P. brassicae resting spore suspension, ensuring that each gram of soil contained 3 × 10
7 resting spores of
P. brassicae. Subsequently, 20 mL of XDS3-6 fermentation broth was applied every 7 days for a total of 5 applications. Disease control was established by inoculating dormant
P. brassicae spore suspension and watering with Gauserime synthetic liquid medium. This was repeated for 20 cabbage plants in each treatment group. Disease incidence was assessed 50 days after inoculation, and data were recorded based on the 6-level grading standard established by Wu [
40]. The treatment procedure for CD1-1 was identical to that of XDS3-6.
4.6. Identification of Actinomycetes
For the purpose of morphological identification, strains XDS3-6 and CD1-1 underwent a structured procedure. Initially, each strain was inoculated onto Gauserime synthetic agar medium using the streaking method. Subsequently, the plates were inverted and incubated at 28 °C for a period of 7 days, during which time the growth characteristics of actinomycetes, as well as the production of soluble pigments in both aerial mycelium and substrate mycelium, were meticulously observed and documented. Following this incubation period, pre-sterilized coverslips were gently inserted into each plate at a 30° angle, with three coverslips placed in each dish. The plates were once again inverted and incubated at 28 °C for an additional 7 days. Subsequently, the coverslips were retrieved, and any excess agar was carefully removed from their undersides. A small quantity of distilled water was applied to a glass slide, and the coverslips were positioned on the slide. Utilizing an optical microscope, the morphological features of the hyphae and spore chains of the biocontrol strains were scrutinized and duly recorded [
41].
For molecular identification, the DNA of strains XDS3-6 and CD1-1 was extracted following the instructions provided by the Magen Bacterial DNA Extraction Kit. Fragment amplification was conducted using the 16S rDNA universal primers 27F (5′-AGAGTTTGATCCTGGCTCAG-3′) and 1492R (5′-TACGGCTACCTTGACGACTT-3′) (Synthesized by Sangon Biotech (Shanghai) Co., Ltd., Shanghai, China). The PCR amplification reaction mixture (50 μL) comprised 25 μL of 2× Taq Master Mix (Takara Biomedical Technology (Beijing) Co., Ltd., Beijing, China), 2 μL each of the upstream and downstream primers, 2 μL of DNA template, and 19 μL of ddH2O. The PCR amplification protocol included an initial denaturation step at 94 °C for 3 min, followed by 29 cycles of denaturation at 94 °C for 30 s, annealing at 55 °C for 30 s, extension at 72 °C for 2 min, and a final extension at 72 °C for 10 min. Subsequently, the PCR product was sent to Shanghai Sangong Co., Ltd. for sequencing. The resulting sequence data were then assembled and compared using SeqMan in order to construct a phylogenetic tree [
42].
4.7. Identification of Hydrolase Produced by Antagonistic Actinomycetes
The actinomycetes CD1-1 and XDS3-6 were separately inoculated onto different culture media, including:
ABP medium (for glucanase screening): Comprising 5.0 g of Poria powder, 1.0 g of K2HPO4 (Sichuan Chuanheng Holdings Group Co., Ltd., Sichuan, China)., 0.1 g of aniline blue (Shanghai Aladdin Biochemical Technology Co., Ltd., Shanghai, China), 1.0 g of KNO3 (King Chemical (Shanghai) Co., Ltd., Shanghai, China), 1.0 g of NaCl (Shanghai Aladdin Biochemical Technology Co., Ltd., Shanghai, China), 0.5 g of MgSO4 (Sinopharm Group Chemical Reagent Co.,Ltd., Shanghai, China), 0.1 g of FeSO4 (Sinopharm Group Chemical Reagent Co.,Ltd., Shanghai, China), 20.0 g of agar (Sinopharm Group Chemical Reagent Co.,Ltd., Shanghai, China), and 1000 mL of distilled water.
Protease screening medium: Prepared by mixing Solution A (240 mL sterile water + 6.4 g skimmed milk powder (Guangzhou Saigouo biotech Co., Ltd), sterilized at 121 °C for 1 min) and Solution B (6.4 g agar + 240 mL sterile water, sterilized at 121 °C for 10 min) post-sterilization.
CMC-Na medium (for cellulase screening): Containing 1.0 g of K2HPO4, 0.5 g of MgSO4, 10.0 g of sodium carboxymethylcellulose (Shanghai Aladdin Biochemical Technology Co., Ltd., Shanghai, China), 0.01 g of FeSO4 (Sinopharm Group Chemical Reagent Co.,Ltd., Shanghai, China), 0.4 g of Congo Red (Shanghai Aladdin Biochemical Technology Co., Ltd., Shanghai, China), 0.5 g of NaCl, 1.0 g of KNO3, 20.0 g of agar, and 1000 mL of distilled water.
Chitin enzyme screening medium: Composed of 0.3 g of KH2PO4 (Sinopharm Group Chemical Reagent Co.,Ltd., Shanghai, China), 10.0 g of colloidal chitin (Shanghai Aladdin Biochemical Technology Co., Ltd., Shanghai, China), 0.7 g of K2HPO4, 0.02 g of FeSO4, 0.5 g of MgSO4, 1.0 g of KNO3, 20.0 g of agar, and 1000 mL of distilled water.
Subsequently, each culture plate was inverted and placed in a 28 °C incubator. After a 7-day incubation period, the growth of the respective strains was observed, and the radius of any transparent circles formed was recorded. The presence of a strain’s growth and the development of a transparent circle indicated the strain’s ability to produce relevant hydrolytic enzymes for digesting specific cell wall components. Generally, a larger transparent circle radius corresponded to a higher hydrolase activity exhibited by the strain.
4.8. Determination of Enzyme Activity in Chinese Cabbage Roots
Chinese cabbage roots bearing the fourth true leaf (10–25 days) were subjected to irrigation with a fermentation filtrate of strains XDS3-6 and CD1-1, each at a concentration of 107 CFU/mL, while Gauserime synthetic liquid medium served as the control. At 5, 9, and 13 days post-inoculation (dpi), three cabbage plants were sampled from both the treatment and control groups. The root systems were meticulously cleaned and dried, and fresh, clean root tissues were excised and promptly preserved at −80 °C in a freezer. Approximately 0.10 g of root tissue was weighed and subsequently homogenized in an ice bath with the addition of 1.00 mL of extraction solution. Centrifugation at 8000× g, 4 °C, for approximately 10 min was conducted to collect the supernatant, which was then maintained on ice for subsequent analysis.
Following the kit instructions, the activities of PAL, POD, PPO, and the contents of proline (Pro) and malondialdehyde (MDA) within the Chinese cabbage roots subjected to the fermentation filtrate of strains XDS3-6 and CD1-1 were quantified according to the operation manual (Beijing Solarbio Science & Technology Co., Ltd., POD:
https://img.solarbio.com/images/202505/1748506976471166084.pdf (accessed on 10 July 2025). PPO:
https://img.solarbio.com/pdf/9-SHSJH/1-ZW/BC0195.pdf (accessed on 10 July 2025). PAL:
https://img.solarbio.com/pdf/9-SHSJH/1-ZW/BC0215.pdf (accessed on 10 July 2025)). Additionally, cabbage root samples were dispatched to Chongqing Bonuoheng Biotechnology Co., Ltd. (Chongqing, China), where the contents of SA, JA, and ET were determined for those cabbage roots treated with XDS3-6 and CD1-1 fermentation filtrate, respectively.
4.9. Determination of Hormone Content in Chinese Cabbage Roots
For JA determination, we ground 0.5 g of plant tissue using a grinding homogenizer, then we added 7.5 mL of a methanol/acetonitrile mixture (80:20, v/v) and vortexed to mix thoroughly. Subsequently, ultrasonic-assisted extraction was conducted. Following extraction, the resultant solution was filtered using filter paper and concentrated through a rotary evaporator. It was then adjusted to volume with methanol to produce the analyte sample. Subsequently, the prepared sample was introduced into the LC-MS system for analytical evaluation. The chromatographic column demonstrated effective separation of JA and other compounds. The mobile phase, comprising methanol and 0.1% formic acid, was employed to ensure the stability and ionization efficiency of JA. The injector facilitated the introduction of the sample into the column, while the mass spectrometer detected and quantified the separated JA.
To extract SA, approximately 0.5 g of fresh plant sample was ground to a fine powder using liquid nitrogen. Subsequently, 5 mL of isopropyl alcohol/hydrochloric acid buffer was added, and the mixture was agitated for 30 min at 4 °C. Following this, 10 mL of methylene chloride was introduced, and the reaction mixture was maintained at 4 °C for an additional 30 min. The ensuing solution was centrifuged at 4 °C and 13,000 rpm for 5 min, and the resultant organic phase, sensitive to light, was carefully separated. The separated organic phase was then subjected to nitrogen blow-drying, then reconstituted in 250 μL–500 μL of methanol containing 0.1% formic acid. The reconstituted solution was further processed by incubating it on a 0.45 μm microorganism pore filter membrane and subsequently analyzed using HPLC-MS/MS.
Gas chromatography was employed to determine ET content. Plant samples were placed into a Soxhlet extractor and subjected to extraction using a methanol and ether mixture (volume ratio: 2:1). Following extraction, the resultant extract was dried over anhydrous sodium sulfate, and the organic solvent was evaporated using a rotary evaporator to yield a concentrated extract. A silica gel-packed column, coated with polydimethylsiloxane, was connected, and the concentrated extract was passed through the glass column for purification. The purpose of this purification step was to eliminate impurities from the sample, thereby enhancing the accuracy and stability of gas chromatography analysis. Ultimately, the purified sample was injected into the gas chromatograph using a syringe for analysis. In the gas chromatogram, the retention times of the ethylene standard and sample peaks exhibited consistency, enabling the calculation of ethylene content in the sample by comparing the peak areas of the standard and sample peaks.
4.10. Determination of Actinomycetes Colonization in Cabbage Roots
The strains XDS3-6 and CD1-1 were inoculated onto Gauserime synthetic agar medium for rifampicin resistance mutagenesis screening. A series of rifampicin concentrations, specifically 5, 10, 20, 30, 40, 60, 90, 120, 150, 210, and 300 μg/mL, were successively employed in sequential cultures until cells capable of thriving at the highest concentration of 300 μg/mL rifampicin were identified. These cells constituted a stable marker strain, displaying minimal alterations in colony morphology on the agar plates. Subsequently, the marker strain obtained from the screening process was cultured on Gauserime synthetic agar medium devoid of rifampicin. After undergoing ten generations of transfer, the marker strain was streaked onto agar plates containing 300 μg/mL rifampicin to assess its growth ability and confirm genetic stability.
Following this, actinomycetes from the marked strain were inoculated into Gauserime synthetic liquid medium without rifampicin. The culture was maintained at 28 °C with agitation at 180 rpm for 7 days, resulting in an actinomycete fermentation filtrate with a concentration of 107 CFU/5 mL. This broth was then used to irrigate the roots of Chinese cabbage, specifically those at the fourth true leaf stage. Root tissue samples were collected at intervals of the 5th, 10th, 15th, 20th, 25th, and 30th days post-irrigation. Soil from the root surface was removed from the collected samples, followed by drying, and the marked actinomycetes present within the cabbage roots were isolated. To initiate the isolation process, cabbage root tissues were disinfected, involving a sequence of steps: 3 min of disinfection with 75% alcohol, followed by 3 min with 2% sodium hypochlorite, and a final 1-min disinfection with 75% alcohol. Subsequently, the tissues were rinsed three times with sterile water, and the sterile water used in the final rinse was examined to ensure thorough disinfection. Approximately 0.1 g of root tissue was then transferred to a sterile mortar, where it was homogenized with 5 mL of sterile water and a small quantity of quartz sand. After a brief period of standing, 100 μL of supernatant was collected and spread onto agar plates containing 300 μg/mL Rif. These plates were inverted and cultured at 28 °C. After 7 days, the presence or absence of growth of the labeled strain was assessed.
4.11. Statistical Analysis
All experiments with corresponding data were repeated at least three times. The data are presented as means and standard deviations. The statistical analysis was performed with SPSS software (version 23.0) using Student’s t-test (* 0.01< p < 0.05, ** 0.001 < p < 0.01, *** p < 0.001) and one-way ANOVA (Tukey’s HSD test, p < 0.05).